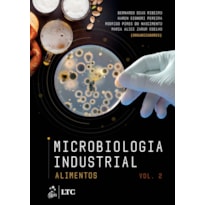

Ordenar por:
Ordenar por:
Cookies: Guardamos estatísticas de visitas para melhorar sua experiência de navegação. Ao continuar navegando, você concorda com a nossa Política de Privacidade.